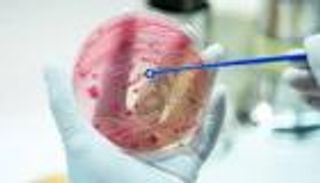
محاربة البكتيريا بـ«الضوء».. بديل آمن للمضادات الحيوية

فن
نوال الزغبي وماجي بو غصن أبرز الحضور في عزاء شقيق المنتج جمال سنان

أقيم عزاء شقيق المنتج اللبناني جمال سنان يوم الأربعاء، حيث حرص عدد من نجوم الفن في لبنان على تقديم واجب العزاء ومواساة عائلة الفقيد.
ومن بين الحضور، حضرت الفنانة اللبنانية نوال الزغبي، إلى جانب الفنانة ورد الخال، والفنان باسم مغنية، والممثل جورج خباز، والممثلة جيسي عبده، وآخرون.

وقفت الفنانة ماجي بو غصن، زوجة المنتج جمال سنان، إلى جانبه لاستقبال العزاء الذي أقيم عقب وفاة شقيقه يوم السبت 30 نوفمبر بعد صراع مع المرض، وفقًا لما أعلن عنه سنان في بيان سابق عبّر فيه عن حزنه الشديد لفقدانه.

على الصعيد الفني، يواصل جمال سنان إنتاج مجموعة من الأعمال الدرامية المميزة، ومن أبرزها مسلسل كامل العدد الذي حقق نجاحًا ملحوظًا في أجزائه المختلفة. شارك في بطولة المسلسل كل من شريف سلامة، دينا الشربيني، ميمي جمال، وآخرون، والعمل من إخراج خالد الحلفاوي.